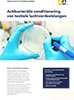

Download hier PDF-bestanden
Materiaal en kleur
Materiaalcertificering
Materiële kennis
Wasvoorschriften
STABU-bestekteksten
Techniek
Montage
Visualisatie
Certificering voor bedrijven
Veelgestelde vragen
Heb je nog vragen? Schrijf ons.
Vind hier antwoorden op het meeste van wat u moet weten of neem rechtstreeks contact met ons op voor verdere hulp en begeleiding.
Als de inlaatlucht en de kamerlucht niet op dezelfde temperatuur zijn, zal een vrije straal door het verschil in luchtdichtheid naar boven of naar beneden buigen. Een verwarmde luchtstroom buigt naar boven af, terwijl een gekoelde luchtstroom naar beneden afbuigt.
U kunt meer over onze voorbeelden lezen in de brochure over FBS-plafondpanelen, waarin we de druk, het luchtvolume, de snelheden in de leefzone en het geluidsvermogensniveau hebben berekend.
Comfortventilatie is een algemene term voor ventilatie in ruimten met eisen aan comfort (temperatuur, luchtsnelheid, relatieve vochtigheid, luchtkwaliteit, enz.).
Lees meer over onze producten voor comfortoplossingen - KE Low Impulse en KE Interior.
De relatieve luchtvochtigheid wordt gedefinieerd als de verhouding tussen de huidige hoeveelheid waterdamp in een luchtmassa en de maximale hoeveelheid waterdamp die de luchtmassa kan bevatten, afhankelijk van de temperatuur en druk van de luchtmassa.
Het dauwpunt is de temperatuur waarbij het waterdampgehalte van een bepaalde luchtmassa, bij afkoeling bij constante druk, vloeibaar wordt tot vloeibaar water. Het dauwpunt beschrijft hoe dicht een luchtmassa verzadigd is met waterdamp. Wanneer de dauwpuntstemperatuur onder het vriespunt daalt, wordt dit vaak het vriespunt genoemd, omdat de waterdampen niet langer dauw genereren, maar in plaats daarvan heesvorst veroorzaken.
De oplossingen van KE-Fibertec zijn actief in fabrieken, magazijnen, kantoren en productiefaciliteiten. We passen de systemen aan uw specifieke behoeften en de kenmerken van de ruimte aan. Bijna elke industriële toepassing kan worden verbeterd met onze technologie.
Ventilatie op basis van textiel maakt gebruik van poreuze materialen om de lucht gelijkmatig over de kamers te verdelen. Het systeem werkt zonder zichtbare kanalen en integreert elegant in plafonds of muren. Het zorgt voor een comfortabel binnenklimaat zonder tocht of geluid.